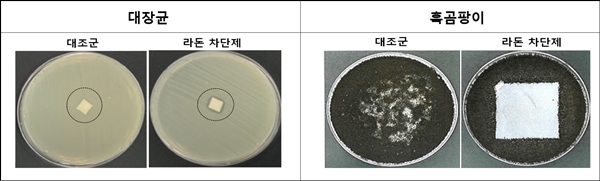
한국원자력연구원이 자체 개발한 항균성 라돈 차단용 도료는 고농도 라돈 방출에도 90% 이상의 라돈 차단율과 우수한 항균, 항곰팡이 특성을 보였다.

[충청뉴스 이성현 기자] 한국원자력연구원이 ㈜해븐코리아(대표이사 김갑수)에 항균성 라돈 차단용 조성 물질 및 제조 방법 관련 특허 기술 5건을 출자해 친환경 기능성 도료를 생산하는 연구소기업을 설립했다고 2일 밝혔다.
연구소기업은 '연구개발특구의 육성에 관한 특별법'에 따라 공공연구기관의 기술을 직접 사업화하기 위해 연구개발특구 내에 설립하는 기업이다.
전북연구개발특구 내 정읍 첨단과학산업단지에 위치한 ㈜해븐코리아는 한양건설㈜의 자회사로 ‘아쿠아키퍼’라는 방수 기능성 도료 등을 생산하고 있다. 향후 출자 기술을 바탕으로 라돈 차폐 기능과 항균성 등이 추가된 ‘라돈키퍼’라는 신제품을 시장에 선보일 계획이다.
주로 밀폐된 공간에서 살아가는 현대인들에게는 실내 공기 중 라돈 농도를 낮추고 제거하는 것이 중요하다.
2018년 침대 매트리스에서 검출돼 큰 논란을 빚은 라돈은 천연방사성 물질이지만 높은 농도에 지속 노출 시 폐암 등을 일으키는 1급 발암 물질이다.
실내 라돈은 오래된 건축물의 갈라진 틈, 지하수 등을 통해 토양에서 유입되거나 건축 자재에서 발생한다. 실내로 유입된 라돈은 충분한 환기를 통해 외부로 내보낼 수 있다. 하지만 겨울철 등 환기가 쉽지 않은 상황에서는 넓은 범위를 원천 차단할 방법이 필요하다.
첨단방사선연구소 방사선융합기술연구부 박종석 박사 연구팀은 라돈을 광범위하고 효과적으로 차단하면서도 인체에 무해한 라돈 차단용 기능성 도료를 개발하는 데 성공했다.
기존에도 라돈 저감용 물질을 벽면에 바르는 라돈 차폐 시공이 개발된 바 있다. 하지만 코팅막이 쉽게 손상돼 라돈 차단 효과를 장기간 유지할 수 없고, 좁은 틈새 사이에는 사용하기 어려웠다. 또, 라돈 저감 효과가 있더라도 휘발성유기화합물(VOCs)을 포함한 소재는 환경에 해롭다.
연구팀은 친환경 소재로 쓰이는 에틸렌비닐아세테이트(EVA)와 라돈을 흡착하는 다공성 물질을 이용해 새로운 조성물을 만드는 데 성공했다. 이온성 계면활성제 등을 첨가한 후 방사선을 조사해 라돈 차단용 물질이 고루 퍼질 수 있도록 표면 특성도 변환했다.
기존에 개발된 도료의 라돈 차단율은 75% 수준인 반면, 연구팀이 개발한 도료는 고농도 라돈 방출에도 90% 이상의 차단율을 보였다. 페인트와 비슷해 시공이 간단하고 발림성이 좋아, 건물 내 균열 또는 틈새 사이로 유입되는 라돈도 쉽게 막을 수 있다.
또 실내외 온도 차이로 발생하는 검은 곰팡이와 각종 질병을 일으킬 수 있는 황색포도상구균, 대장균 등의 세균에 우수한 항곰팡이, 항균 특성도 보였다. 새집증후군의 주원인인 폼알데하이드도 효과적으로 차단한다.
이번 성과는 2019년부터 과학기술정보통신부의 방사선안전소재기술개발사업의 지원을 받아 진행했다. 기초 기술개발부터 시작해 시제품 제작, 공인시험 인증까지 마쳤다.
주한규 원장은 “국민의 건강과 삶의 질을 높이는 대체 불가 방사선 융합 강점 기술을 지속 육성해 우리 연구소기업인 ㈜해븐코리아의 신규 제품 개발에도 적극 지원하겠다”라고 말했다.


